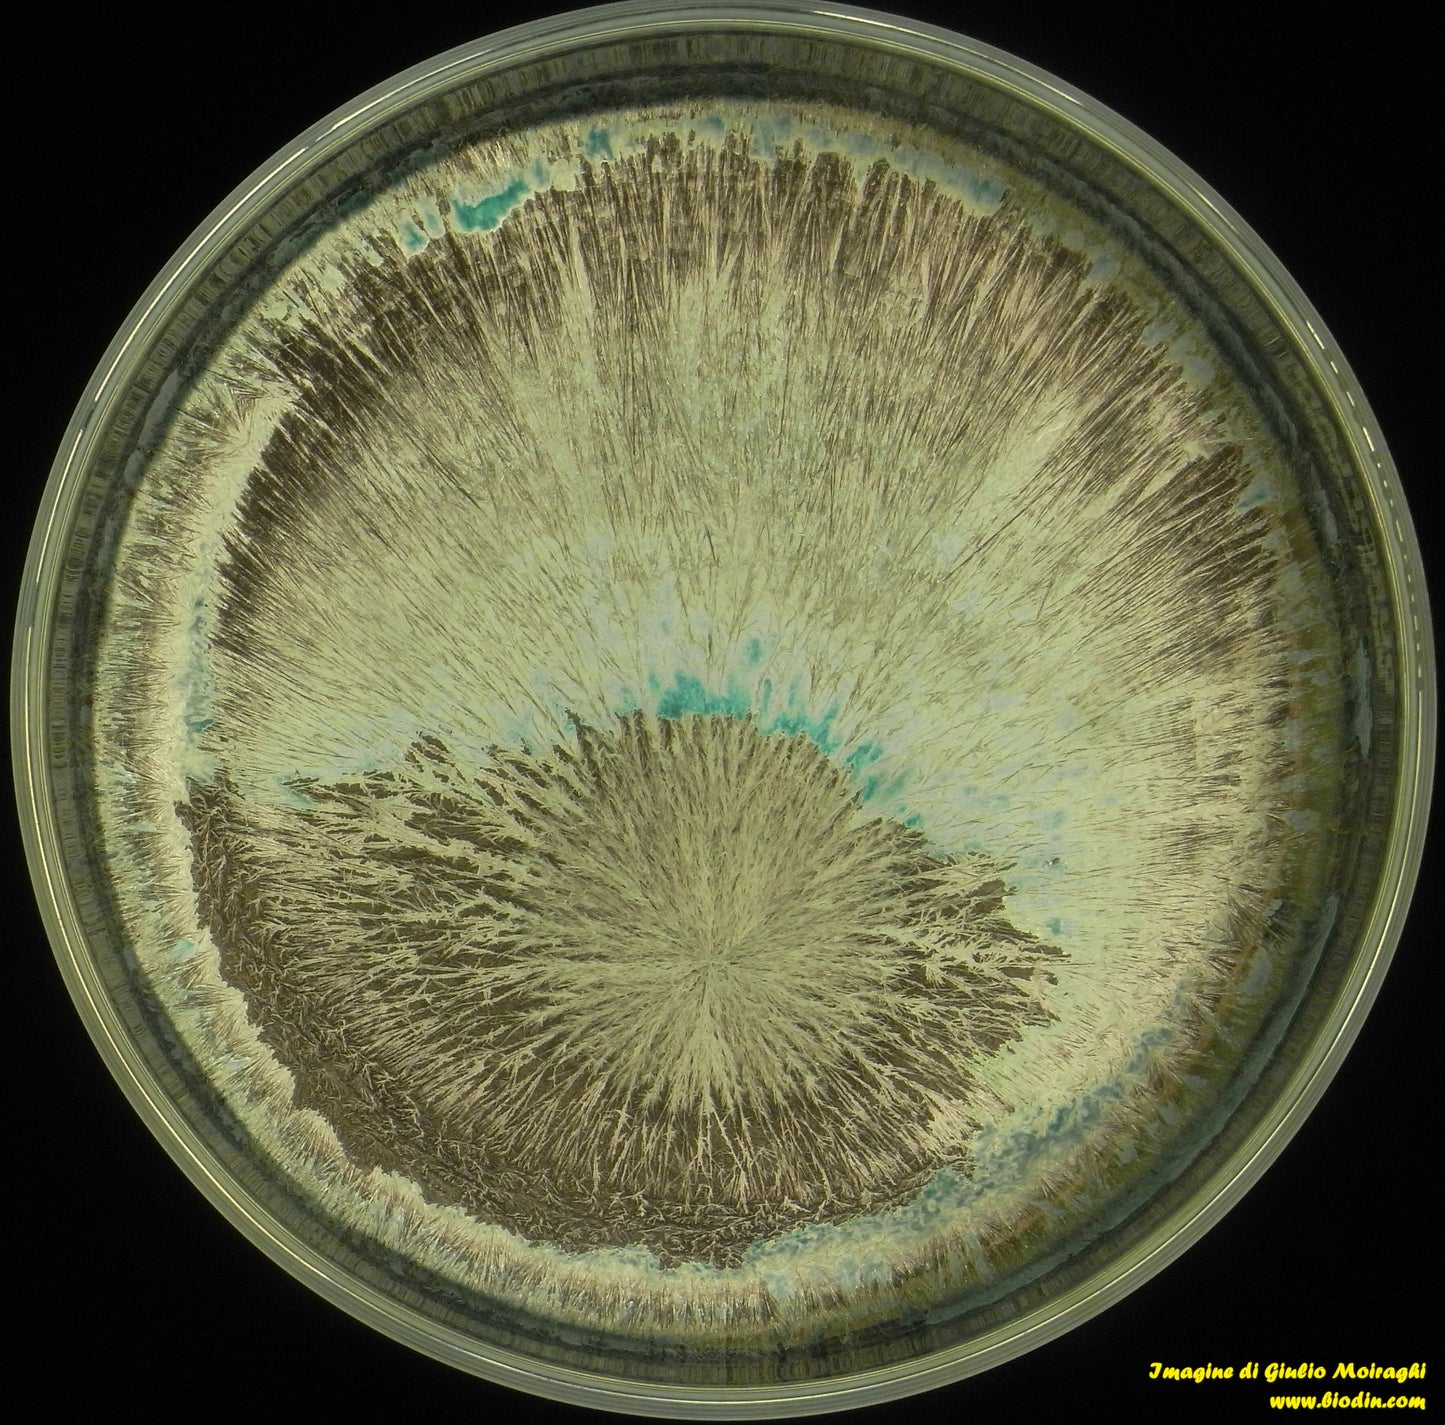

€30,00 EUR
Imposte incluse.
Spese di spedizione calcolate al check-out.
531 PREPARATO DI MICA
Have a question?

531 PREPARATO DI MICA
€30,00 EUR
Dettagli
IL PREPARATO DI MICA
R. Steiner parla dell'uso della mica in una conferenza tenuta il 17 febbraio 1923 a Dornach (O.O. 349) dicendo che la mica ha preceduto la formazione della silice. La mica è composta di feldspato, argilla e silice.
A breve pubblicherò un volumetto sul preparato di mica che ho chiamato anche 531.
30 grammi x ettaro. Dinamizzare 60 minuti al mattino come il 501 e spruzzare a goccia fine sopra la pianta
- favorisce la formazione della struttura e "sostiene" della pianta
- riporta elasticità nella pianta (vecchia) perchè le forze eteriche vengono attirate verso l'alto portando forze di "resurrezione" e di transustanziazione
- calamita le forze eteriche formatrici cosmiche nella pianta